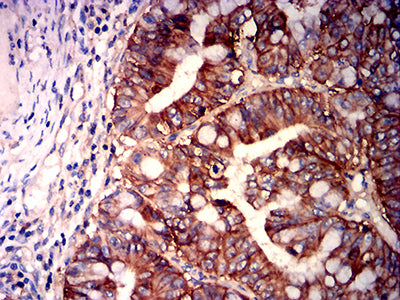

-
分类: 科研抗体货号: 31942别名:应用:反应种属: Human
-
分类: 科研抗体货号: 31958别名: BSG; OK; 5F7; TCSF; EMMPRIN应用: IHC,FCM反应种属: Human
-
分类: 科研抗体货号: 31941别名: CA125应用: FCM反应种属: Human
-
分类: 科研抗体货号: 31957别名: MME; NEP; SFE; CALLA; CMT2T; SCA43应用: FCM反应种属: Human
-
分类: 科研抗体货号: 31940别名: LILRA4;ILT7应用: WB,IF,FCM反应种属: Human
-
分类: 科研抗体货号: 31956别名: DRRS; HSAL4; ZNF797; dJ1112F19.1应用: WB,FCM反应种属: Human, Mouse
-
分类: 科研抗体货号: 31965别名: DR3; TR3; DDR3; LARD; APO-3; TRAMP; WSL-1; GEF720; WSL-LR; PLEKHG5; TNFRSF12应用: IHC,FCM反应种属: Human
-
分类: 科研抗体货号: 31955别名: DRRS; HSAL4; ZNF797; dJ1112F19.1应用: WB,FCM反应种属: Human, Mouse
-
分类: 科研抗体货号: 31963别名:应用:反应种属: Human
-
分类: 科研抗体货号: 31954别名: DRRS; HSAL4; ZNF797; dJ1112F19.1应用: WB,FCM反应种属: Human, Mouse

鄂公网安备42018502007531号
鄂公网安备42018502007531号

